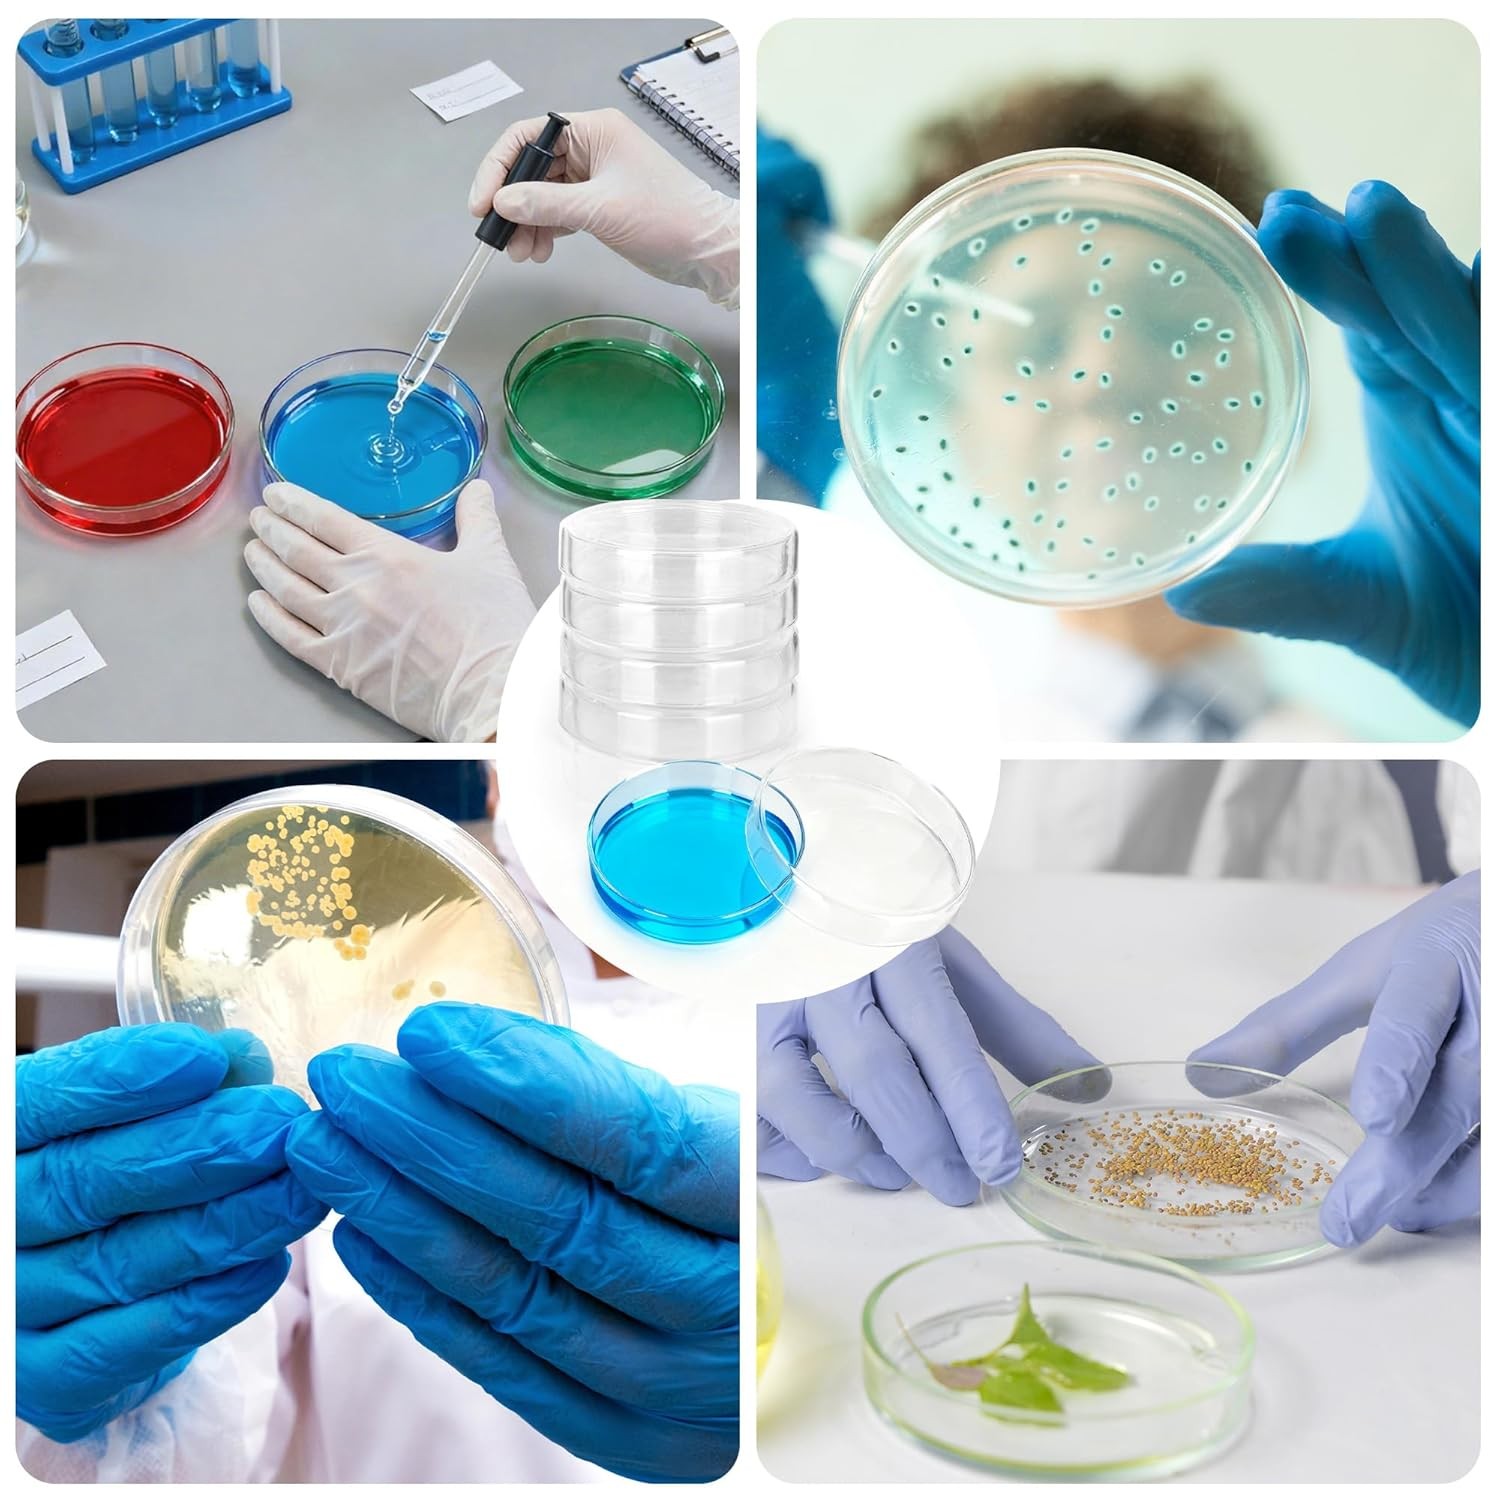
10Pcs 60mm Glass Petri Dishes with Lids Autoclavable Lab Petri Plates Reusable

Product categories
10Pcs 60mm Glass Petri Dishes with Lids Autoclavable Lab Petri Plates Reusable
$9.49$18.99
Returns & Exchanges within 30 days
Any return for unsatisfied item(s) is available within 30 daysMoney Back Guarantee
A full refund within one week upon receiving your returnFree Shipping
Enjoy free shipping on all orders $50Description
Information
Recommended Products
TRUSTED STORE
CERTIFIED SECURE